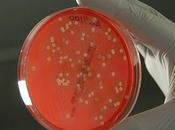
Cultivo tejidos animales

Daniel Palomino
 Descripción
Descripción
Graduado en Ciencias Ambientales.
Soy una persona alegre y positiva, me encanta leer, el cine y sobre todo la naturaleza
compartido
MIS BLOGS
-
VerdeZona
http://verdezona.blogspot.com.es/
Blog dedicado al medioambiente donde se tratan temas interesantes, debates, noticias y curiosidades de este tema
ÚLTIMOS ARTÍCULOS (133)
-
Libros tradicionales vs ebooks

La pelea empieza de nuevo y esta vez se suben al ring los libros tradicionales y los libros electrónicos, o comúnmente conocidos como ebooks.Ambos libros... Leer el resto
Publicado el 06 febrero 2015 100% VERDE, CIENCIA, MEDIO AMBIENTE -
Tipos de nubes

En estos días que el tiempo está empezando a hacer de las suyas y llueve bastante, por lo menos por aquí, vamos a ver los distintos tipos de nubes que existen. Leer el resto
Publicado el 30 enero 2015 100% VERDE, CIENCIA, MEDIO AMBIENTE -
Agricultura lunar

¿Alguna vez habéis oído decir a las personas más ancianas algo relacionado con la agricultura y la luna?Si siembras cuando esta la luna llena crecerá más rápido... Leer el resto
Publicado el 23 enero 2015 100% VERDE, CIENCIA, MEDIO AMBIENTE -
Los combustibles del futuro

Hola a todos, estamos otro viernes aquí para daros lo mejor de nosotros.Esta semana el tema que voy a tratar es de los combustibles, pero no los típicos... Leer el resto
Publicado el 16 enero 2015 100% VERDE, CIENCIA, MEDIO AMBIENTE -
¿Incompetencia o mafia dentro de la sanidad?

¡Hola a todos y Feliz Año!Este es el primer post del 2015 y quería en un principio dedicaros un post interesante con un tema medioambiental profundo, pero me... Leer el resto
Publicado el 09 enero 2015 100% VERDE, CIENCIA, MEDIO AMBIENTE -
EcoNavidades en la Universidad de Jaén

Esta semana volvemos con las navidades y es que, después de estar preparándome para el examen del curso que he tenido hoy (Energías Renovables), quiero comparti... Leer el resto
Publicado el 19 diciembre 2014 100% VERDE, CIENCIA, MEDIO AMBIENTE -
REdecorando en casa para estas Navidades
 Publicado el 12 diciembre 2014
100% VERDE,
CIENCIA,
MEDIO AMBIENTE
Publicado el 12 diciembre 2014
100% VERDE,
CIENCIA,
MEDIO AMBIENTE
-
Cultivo de tejidos de animales
Por petición de una de nuestras lectoras ( Shweta Sissodia ) esta semana me voy a centrar en el tema de los tejidos de animales para cultivo. Esto en mi carrer... Leer el resto
Publicado el 05 diciembre 2014 100% VERDE, CIENCIA, MEDIO AMBIENTE -
Erosión, uno de los principales problemas a nivel mundial

La erosión del suelo es la forma de erosión que más afecta al funcionamiento del ecosistema, ya que supone una disminución considerable de la calidad del suelo. Leer el resto
Publicado el 22 mayo 2014 100% VERDE, CIENCIA, MEDIO AMBIENTE -
La Huella Ecológica

¿Habéis oído alguna vez algo sobre la Huella Ecológica?Si no es el caso o si todavía no lo tienes muy claro, esta entrada quizás te ayude a entenderla, y es... Leer el resto
Publicado el 14 mayo 2014 100% VERDE, CIENCIA, MEDIO AMBIENTE -
Ranking de fotos del planeta IV

Como iba siendo ahora nos ponemos al día con los rincones del planeta que merecen la pena ver por lo menos, en fotos.Esta vez las fotos nos las trae... Leer el resto
Publicado el 02 mayo 2014 100% VERDE, CIENCIA, MEDIO AMBIENTE -
Reutilizando; nuevas ideas

Como os dije en la entrada Mejor reutilizar que tirar podemos darle una segunda oportunidad a aquellas cosas que van a ir a la basura y así poderlas usar de... Leer el resto
Publicado el 30 abril 2014 100% VERDE, CIENCIA, MEDIO AMBIENTE -
McDonald´s, su alteración en el cambio alimenticio y su contribución al cambio...

Siento el retraso de la entrada pero entre unas cosas y otras en esta semana he estado un poco más ocupado de lo normal. El tema de hoy es sobre... Leer el resto
Publicado el 25 abril 2014 100% VERDE, CIENCIA, MEDIO AMBIENTE
